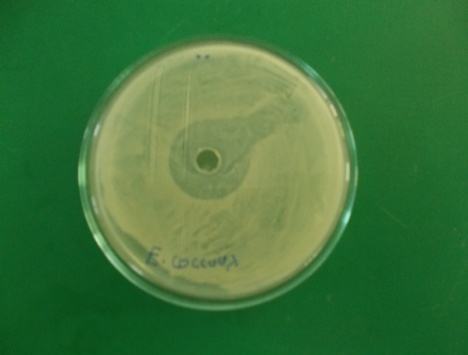
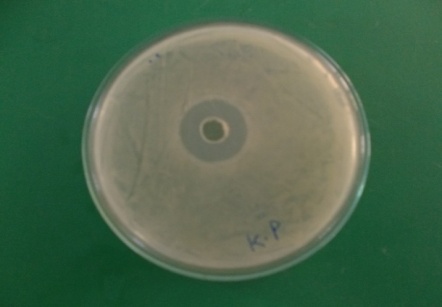
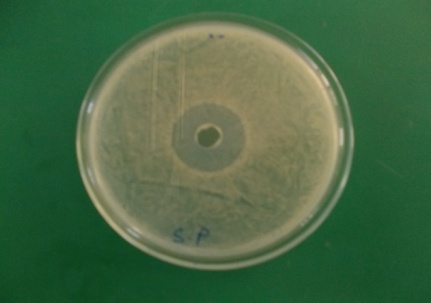
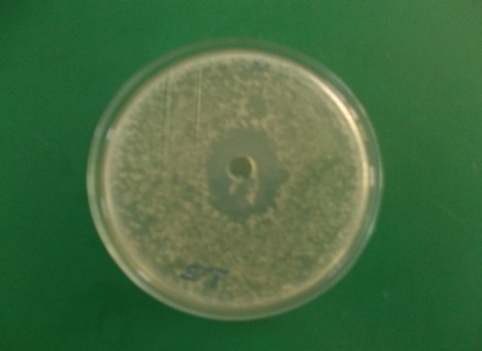

Int J Pharm Pharm Sci, Vol 6, Issue 9, 143-146Original Article
STUDY ON IN-VITRO ANTIBACTERIAL ACTIVITY OF MUSHROOM COLLECTED FROM JABALPUR REGION
LOKNATH DESHMUKH1, SUNEEL KUMAR3, RAVINDRA PRASAD AHARWAL3, R.C. RAJAK2, SARDUL SINGH SANDHU3*
1Department of Microbiology, Govt. V. Y. T. P. G. Autonomous College Durg (C.G.) India, 2SGH Center for Rural Biotechnology and Management, Jabalpur, (M.P.) India, 3Fungal Biotechnology and Invertebrate Pathology Laboratory, Department of Biological Sciences, Rani Durgawati University, Jabalpur 482001, (M.P.) India.
Email: ssandhu@rediffmail.com
Received: 28 Jun 2014 Revised and Accepted: 15 Aug 2014
ABSTRACT
Objective: The aim of the present investigation is to examine the collected wild mushroom for their in-vitro antibacterial activity and cultivation of potential mushroom strains.
Methods: screening of mushrooms for in-vitro antibacterial activity against six pathogenic bacteria i.e. Bacillus subtilis (B. subtilis), Streptococcus pyogenes (S. pyogenes), Escherichia coli (E. coli), Klebsiella pneumoniae (K. pneumoniae), Salmonella typhimurium (S. typhimurium), Enterococcous sp. (E. coccous) by agar well diffusion method.
Result: Pleurotus sajor-caju showed the maximum zone of inhibition against all the pathogenic bacteria.
Conclusion: From the result we conclude that the mushroom Pleurotus sajor-caju is potent for antibacterial activity.
Keywords: Mushrooms, Bioactive compounds, Antibacterial activity, Calcium sulphate, Wheat straw.
INTRODUCTION
In the present scenario scientists are taking more interest in the medicinal properties of the mushrooms than in their basic value as a source of food. Medicinal mushrooms are now the subject of study for many ethno botanists and medical researchers. Of the 14,000 to 15,000 species of mushrooms in the world, around 700 have known medicinal properties, but 1800 species of mushrooms are thought to possess potential medicinal attributes [1]. According to Patel et al. [2] mushrooms have been used as food supplement from times immemorial not only for their flavor, aroma and nutritive values but also for their medicinal properties. Wild mushroom holds a variety of bioactive compounds that have made it possible to be used as an impending source for the improvement of medicine and nutraceuticals. These bioactive compounds have been employed as immune-modulator, anti-fibrotic, anti-inflammatory, anti-diabetic, anti-viral, antioxidant and antimicrobial agents [3-6]. Al-Fatimi et al. [7] studied on the mushroom Podaxis pistillaris used in Yemeni ethno-medicine and found that it exhibit antibacterial activity against Staphylococcus aureus, Micrococcus flavus, Bacillus subtilis, Proteus mirabilis, Serratia marcescens and Escherichia coli. In another study it was found that the solvent extract of Lentinus tuberregium show antimicrobial activity against bacteria and yeast [8]. Antrodia camphorata is a unique mushroom of Taiwan, which has been used as a traditional medicine for protection of diverse health related conditions. Pandiarajan et al. [9] study the antimicrobial activity and heavy metal accumulation of oyster mushroom by growing on two different substrate. The ethanol and acetone extract of these fungi showed the antimicrobial activity against selected microorganism done by agar well diffusion and disc method. Different types of agriculture wastes are utilized for the cultivation of various mushrooms [10]. The present study was carried out to isolate and identify mushroom from various region of Dumna forest Jabalpur (M.P.) (India) and study their antibacterial bioactive compounds produced by these mushrooms.
MATERIALS AND METHODS
Collection of Mushroom sample: Sampling of mushrooms was done from the various region of Dumna forest, Jabalpur, (M.P.)(India). The material was brought to the laboratory in sterile bags and preserved at room temperature.
Identification of Mushroom
On the basis of their morphological appearance and microscopic characters such as colour, shape and growth of cultured colonies etc, the fruiting bodies of all the 12 collected mushrooms were characterized and identified [11]. Obtained data was then compared with the descriptions of mushroom species given in the existing literature. When the morphological investigation fails to reveal the identity of the isolated mushroom, the species is marked as unidentified. Analysis of the antibacterial activity, was carried out on all species, identified and unidentified.
Test organisms
In the present study antibacterial activity of mushroom was assessed against 6 bacterial strains. The pathogenic bacteria Escherichia coli, Salmonella typhimurium, Klebsiella pneumoniae, Enterococcus sp., Bacillus subtilis and Streptococcus pyogenes were preserved on nutrient agar medium at 37°C in bacteriological incubator. The pure cultures of above mentioned bacterial strains were obtained from Microbial Type Culture Collection (MTCC), Chandigarh, India.
Antibacterial activity
150 ml of Potato Dextrose Broth (PDB) was prepared in 250 ml flasks and autoclaved at temperature 121oC for 20 minutes. The medium was inoculated with various mushroom cultures and incubated at 28±1°C. After 7, 14 and 21 days of incubation the cultured broths were filtered to obtain crude extract which is then further proceeded for testing the antibacterial activity by agar well diffusion methods. Finally plates were observed for zones of inhibition and their diameter was measured with the help of Hi-Antibiotic zone scale, Hi Media Laboratories Mumbai.
Cultivation of Pleurotus sajor-caju
Cultivation of mushroom Pleurotus sajor-caju was done at small scale in laboratory. spawns were prepared in the laboratory by using wheat grains as substrate. Next day mother-culture (inoculums) of mushroom was inoculated in bottles. Now bottles were incubated at room temperature (26 to 28±1oC) for one week (or required time for growth). All the bottles were shaked at regular intervals during the incubation period. After preparation of spawn, raw material (wheat straw) was chopped in small pieces about 2-4 cm and soaked overnight in tap water and treated with hot water or steam for one hour. Next day soaked wheat straw treated with pasteurization process by hot water or steam (65°C for 1 hour) treatment. Thereafter, excess water was removed and cooled at room temperature. Spawn was mixed with wheat straw and filled in sterilized polythene bags. Then all bags leaved in dark condition at 28 ±1°C for 22 to 25 days for the growth of mushroom. Less humidity was required, spraying of water was done during the growth to complete water requirement.
RESULT
Survey and collection of mushroom
The mushroom samples were collected from various part of the Dumna forest Jabalpur (M.P.) (India). A total of 12 mushrooms isolated in this study are depicted in (Table 1).
Table 1: List of Mushroom strains collected from different Places of Dumna region
| S. No. | Name of mushroom | Substrate |
| 1. | Ganoderma lucidium | Domestic waste |
| 2. | Coprinus sp. | Sugar cane litter |
| 3. | Agaricus caessaria | Forest litter |
| 4. | Agaricus amanita | Soil |
| 5. | Termitomyces heimi natarajan. | Decaying wood |
| 6. | Ganoderma sp. | Decaying wood |
| 7. | Unidentified | Sugar cane |
| 8. | Coprinus comatus | Forest litter |
| 9. | Agaricus pantherina | Soil |
| 10. | Leucoagaricus sp. | Decaying wood |
| 11 | Pleurotus sajor-caju | Forest litter |
| 12 | Unidentified | Wood |
Screening of collected Mushrooms for Antibacterial Activity
In the present study, twelve strains of mushrooms were screened for antibacterial activity against pathogenic bacteria by agar well diffusion method i.e. Bacillus subtillis, Straprococcus pyogenes, Escherichia coli, Klebsiella pneumoniae, Enterococcous sp. and Salmonella typhimurium.

Fig. 1: Broad spectrum activity of selected endophytic fungi against 6 pathogenic bacteria
Pleurotus sajor-caju showed maximum zone of inhibition against Klebsiella pneumoniae, (22 mm) Bacillus subtilis (24 mm) Streptococcus pyogenes (25 mm) E. coli (20 mm) Enterocccous sp. (26 mm) and Salmonella typhimurium (25 mm) depicted (Table 2). Similarly, Ganoderma lucidium showed maximum zone of inhibition against Salmonella typhimurium (20 mm), Bacillus subtilis (17 mm), Enterococcus sp. (15 mm) and Escherichia coli (13 mm), but it showed least activity against Streptococcus pyogenes (11 mm) and Klebsiella pneumoniae (10).
The two mushroom Coprinus comatus and Boletus edulis gave approximately equally result against all the pathogenic bacteria as shown (fig. 1). The Agaricus amanita and Termitomyces heimi natarajan were showed highest activity against Bacillus subtilis but there is no zone of inhibition against E. coli. Some other mushroom like Coprinus sp. Clitocybe sp., Ganoderma sp., Leucoagaricus and two unidentified mushroom also gave their antibacterial activity against the pathogenic bacteria.
 |
|
| Bacillus subtillis | Enterococcus sp. |
|
|
| Klebsiella pneumoniae | Streptococcus pyogenes |
 |
|
| Escherichia coli | Salmonella tybhimurium |
Fig. 2: Results of antibacterial activity of Pleurotus sajor-caju against test organisms
Cultivation of Pleurotus sajor-caju
Cultivation of mushrooms showing maximum in-vitro antibacterial activity (Pleurotus sajor-caju) was done in the laboratory. Wheat grain along with calcium carbonate and Calcium Sulphate was used as substrate for preparing the spawn. The inoculated spawns were incubated at room temperature. Afterwards proper sterilization was done and excess water was confiscated from the wheat straw these were, then packed in the sterilized polythene bags and inoculated with the spwan of Pleurotus sajor-caju then incubated at 28±1oC in a dark place for 20 to 25 days.


Fig. 3: Production of potent Mushroom (Pleurotus sajor-caju)
DISCUSSION
Natural products not only provide valuable components but also an important source of bioactive compounds that provide lead information for developing useful synthetic compounds. Mushrooms contain a large number of biologically active components that impart health benefits and protection against degenerative diseases.
They have been traditionally used in all over world for treatment of a variety of chronic diseases. Mushroom showed potential antimicrobial activity against the pathogenic organism due to the presence of bioactive compounds like terpenoids, alkaloids and phenol which exhibit antimicrobial activity [12].
Table 2: Screening of Mushroom against 6 pathogenic bacterial strains
| S. No. | Name of Mushroom | Zone of inhibition (in mm) | |||||
| B. subtilis | S.pyogenes | E. coli | K. pneumoniae | Enterococcus sp. | S. typhimurium | ||
| 1. | Ganoderma lucidium | 17 | 11 | 13 | 10 | 15 | 20 |
| 2. | Coprinus sp. | 8 | - | - | 12 | 10 | - |
| 3. | Clitocybe sp. | 12 | - | 5 | 10 | 7 | 11 |
| 4. | Agaricus amanita | 14 | 6 | - | 11 | 12 | 9 |
| 5. | Termitomyces heimi natarajan | 13 | - | - | 6 | 5 | 11 |
| 6. | Ganoderma sp. | 11 | 5 | - | - | 10 | 5 |
| 7. | Unidentified | 12 | - | 11 | - | 6 | 10 |
| 8. | Coprinus comatus | 14 | 10 | 12 | 12 | 13 | 10 |
| 9. | Boletus edulis | 10 | 10 | 7 | 13 | 11 | 7 |
| 10. | Leucoagaricus sp. | - | - | 5 | 11 | 12 | - |
| 11. | Pleurotus sajor-caju | 24 | 25 | 20 | 22 | 26 | 25 |
| 12. | Unidentified | 5 | 9 | 6 | 10 | 5 | - |
In another study by Kalyoncu et al. [13] the ethanolic extracts of Armillaria melliea mycelium showed antibacterial effect against Sarcina lutea, however, no activity was observed upon other Gram-positive bacteria. Tambeker et al. [14] reported the antimicrobial ability of several extracts of Pleurotus sajor-caju against Escherichia coli, Enterococcus aerogenes, Pseudomonas aeruginosa and Klebsiella pneumoniae were most sensitive to ethanolic, methanolic and xylene extracts. Ndyetabura et al. [15] investigated that the extract of Tanzanian C. cinereus & reported potential antimicrobial activity against a number of organisms like Escherichia coli, Candida albicans and Aspergillus niger. These new bioactive compounds isolated from these mushroom can be used in the development of new drugs for cure of diseases. Similarly, Jagdish et al. [16] found that the aqueous extract of Pleurotus florida and Pleurotus aureoviosus showed the antimicrobial activity against S. aureus, P. aeruginosa and Candidia albicans. The cultivation of Pleurotus sajor-caju was done in the laboratory at a small scale on the wheat straw and was used as substrate for maximum production of the mushroom for extraction of bioactive compounds. Patrabansh et al. [17] cultivated Pleurotus sajor-caju on three different substrate alone like Populus deltoides, Eupatorium adenophorum and sericulture waste mixed with paddy straw. It was reported that when Pleurotus sajor-caju used alone on these three substrate gave the best result as compare to other. In another study it was found that Cordyceps militaris contain a number of bioactive compounds like cordycepin, cordycepic acid, vitamin, adenosine and enzymes etc. The bioactive molecule cordycepin was isolated from Cordyceps militaris having a broad spectrum biological activity [18, 19].
CONCLUSION
In the present study a number of mushrooms were isolated from the different site of Jabalpur (M.P.) (India). A total 12 mushrooms were isolated such as Ganoderma lucidium, Pleurotus sajor-caju, Leucoagaricus sp., Boletus edulis, Coprinus comatus, Ganoderma sp., Termitomyces heimi natarajan, Agaricus amanita, Clitocybe sp., Coprinus sp. and two were unidentified. The Pleurotus sajor-caju showed the maximum zone of inhibition against Enterococcus sp., S. typhimurium S. pyogenes, B. subtilis, K. pneumoniae and E. coli. Therefore, the present study reveals that mushrooms are not only valuable sources of nutrition but also are important sources of bioactive compounds against a number of pathogenic bacteria and other pathogens. They could play a vital role to cure lot of human diseases. However, intensive and extensive investigations are needed to exploit their valuable therapeutic uses.
CONFLICT OF INTEREST STATEMENT
We declare that we have no conflict of interest.
ACKNOWLEDGEMENTS
The authors wish to thanks the Director of SGHRBM, Mrs. Ranjeet Kaur Sandhu Jabalpur, India for providing laboratory facility and the Head of department Govt. V. Y. T. P. G. Autonomous College Durg, India for dissertation leave to Loknath Deshmukh.
REFERENCES
- Chang ST, Buswell JA. Ganoderma lucidium (Curt. ex Fr.) P. Karst (Aphylophoromycetedae)-a mushrooming medicinal mushroom. Int J Med Mush 1999;1:139-46.
- Patel Y, Naraian R, Singh VK. A Review on Medicinal Properties of Pleurotus species (Oyster Mushroom). J World Fung Plant Biol 2012;3(1):01-12.
- Kalač P. Chemical composition and nutritional value of European species of wild growing mushrooms:a review. J Food Chem 2009;113:9-16.
- Borchers A, Keen CL, Gershwin ME. Mushrooms, tumors, and immunity:an update. J Exp Biol Med 2004;229:393-406.
- Poucheret P, Fons F, Rapior S. Biological and pharmacological activity of higher fungi:20-Year retrospective analysis. J Mycologie 2006;27:311-33.
- Gonçalves O, Pereira R, Gonçalves F, Mendo S, Coimbra MA, Rocha SM. Evaluation of the mutagenicity of sesquiterpenic compounds and their influence on the susceptibility towards antibiotics of two clinically relevant bacterial strains. J Mutat Res 2011;723:18-25.
- Al-Fatimi MMA, Julich WD, Jansen R, Lindequist U. Bioactive components of the traditionally used Mushroom Podaxis pistillaris. J Evidence Based Complement Alternat Med 2006;3(1):87-92.
- Manjunathan J, Kaviyarasan V. Solvent Based Effectiveness of Antibacterial Activity of Edible Mushroom Lentinus tuberregium Fr. Int J Pharm Tech Res 2010;2(3):1910-2.
- Pandiarjan G, Govindaraj R, Maeeswaran J, Makesh BK. Antibacterial activity and Heavy metal accumulation of edible oyster mushroom (Pleurotus sajor-caju) grown on two substrate. Int J Phar Pharmac Sci 2012;4(2):238-40.
- Chiu SW, Law SC, Ching ML, Cheung KW, Ming JLO. Themes for mushroom exploitation in the 21st century sustainability, waste management and conservation. J Gen Appl Microbiol 2000;46:269-82
- Manoharachary C, Sridhar K, Singh R, Suryanarayanan TS, Rawat S, Johri BN. Fungal Biodiversity:Distribution, Conservation and Prospecting of Fungi from India. J Current Sci 2005;89(1):1-10.
- Dikeman CL, Bauer LL, Flickinger EA, Fahey GC. Effects of stage of maturity and cooling on the chemical composition of selected mushroom varieties. J Agri Food chem 2005;53;1130-8.
- Kalyoncu F, Oskay M, Salam H, Erdoan TF, Tamer AÜ. Antimicrobial and antioxidant activities of mycelia of 10 wild mushroom species. J Med Food 2010;13:415-9.
- Tambekar DH, Sonar TP, Khodke MV, Khante BS. The Novel antibacterial from two edible mushroom: Agaricus bisporus and Pleurotus sajor-caju.. Int J Pharmacol 2010;2:584-7.
- Ndyetabura T, Lyantagaye SL, Mshandete AM. Antimicrobial activity of Ethyl extracts from edible Tanzanian Coprinus cinereus (Schaeff) S. Grays. Cultivated on grasses supplemented with cow dung manure. ARPN J Agri Biolo Sci 2010;5:79-85.
- Jagadish LK, Krishnan VV, Shenbhagaraman R, Kaviyarasan V. Comparative study on the antioxidant, anticancer and antimicrobial property of Agaricus bisporus (J. E. Lange) Imbach before and after boiling. Afr J Biotechnol 2009;8(4):654-61.
- Patrabansh S, Madan M. Studies on cultivation, biological efficiency and chemical analysis of Pleurotus sajor-caju (FR.) singer on different Bio-waste. J Acta Biotechnologica 1997;17:(2):107-22.
- Tuli HS, Sandhu SS, Sharma AK. Pharmacological and therapeutic potential of Cordyceps with special reference to Cordycepin. J Biotech 2013 DOI 10.1007/s13205-013-0121-9.
- Cunningham KG, Ma son W, Spring FS, Hutchinson SA. Cordycepin a metabolic product isolated from cultures of Cordyceps militaris (L.) Link. J Nature 1950;166:949–54.